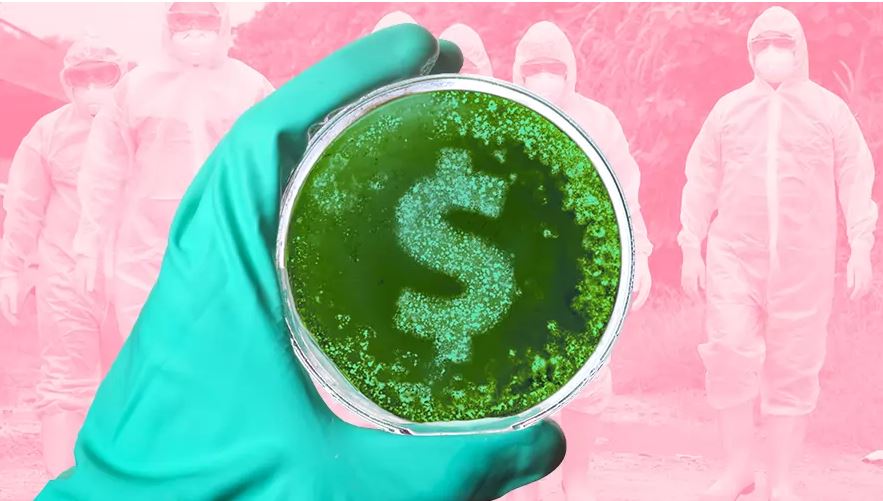
¿Cuál es el impacto económico de una pandemia?

El coronavirus 2019-nCov cobró este viernes su víctima número 41, mientras el número de personas infectadas superó los mil en los 10 países que hasta ahora han reportado este tipo de casos.
Sin embargo, la Organización Mundial de la Salud (OMS) determinó el jueves que aún es muy temprano para declarar una emergencia sanitaria por coronavirus.
Dado que China representa, en la actualidad, casi una quinta parte de la economía mundial, según el Fondo Monetario Internacional (FMI), las secuelas económicas de la enfermedad pueden ser importantes, incluso si esta no llega al nivel de una pandemia.
Para dimensionar las consecuencias negativas del nuevo coronavirus, revisamos qué pasó con la economía mundial cuando otras enfermedades presentaron un alto número de contagios en poco tiempo.
¿Primero, de qué hablamos cuándo decimos brote o pandemia?
Cuando hablamos de un brote, nos referimos al incremento súbito de casos de una enfermedad limitado a un área geográfica en específico, según los Centros para el Control y Prevención de Enfermedades (CDC).
¿Y cuándo se habla de pandemia? Esta clasificación se refiere a una epidemia que se ha extendido por varios países o continentes y afecta a un gran número de personas.
Ahora, ¿cuánto le han costado las pandemias a la economía mundial?
Pandemia de Síndrome Respiratorio Agudo Grave (SARS, por sus siglas en inglés)
Duración: Noviembre de 2002 a julio de 2003
Origen: China
Muertos: 774, según datos de la OMS.
Costo: Estimaciones del Banco Mundial señalan que la epidemia tuvo un impacto económico de 54 mil millones de dólares.
En un reporte de 2013 la institución destacó que en este tipo de casos la confianza de las empresas y los consumidores se derrumba, el absentismo de los trabajadores aumenta drásticamente y los servicios públicos fallan.
"Este síndrome, SARS, es una amenaza para la salud mundial", dijo en su momento Harlem Brundtland, director general de la OMS.
Es precisamente este caso el que despierta ‘miedo’ por el nuevo coronavirus, pues esta también tuvo su origen en China.
Pandemia de la influenza AH1N1
Duración: abril de 2009 a agosto de 2010
Origen: Estados Unidos y México
Muertos: En un inicio, la OMS ubicó la cifra en 18 mil 631 muertos. Sin embargo, un estudio hecho en 2013 remarcó que la cifra era aproximadamente 10 veces más grande.
Los investigadores señalaron que en el tiempo que duró la pandemia fallecieron entre 123 mil y 203 mil personas. De estas, entre 62 y 85 por ciento se registraron en personas menores de 65 años.
Costo: Se calcula que el daño a la economía mundial estuvo en un rango de 45 mil millones a 55 mil millones de dólares, según un estudio del OMS.
México, uno de los países de origen del virus, vio un golpe de 0.7 por ciento de su Producto Interno Bruto, equivalente a 57 mil millones de pesos, según datos de la Secretaría de Salud en 2009.
Brote de ébola en África
Duración: de agosto de 2014 a junio de 2016
Origen: Guinea
Muertos: La cifra llegó a los 11 mil 325 fallecidos, según datos del CDC, de 28 mil 652 personas contagiadas.
Costo: 53 mil millones de dólares, según el informe Un mundo en riesgo de la Organización Mundial de la Salud.